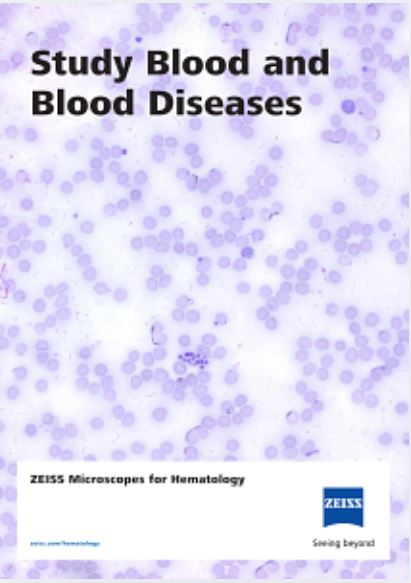

ZEISS Axiolab 5
Optimice la eficiencia de los laboratorios clínicos y biomédicos con la microscopía inteligente
Axiolab 5 satisface las rigurosas exigencias de los laboratorios clínicos y biomédicos, y representa la combinación perfecta de diseño ergonómico y rapidez. Benefíciese de una forma completamente nueva de documentación digital con Axiolab 5 y de la cámara de microscopio Axiocam 208 color. Solo tendrá que enfocar la muestra y pulsar un botón para conseguir imágenes nítidas en color real. Smart Microscopy se encargará del resto.
✅ Obtenga imágenes digitales con tan solo pulsar un botón, que tengan un aspecto exactamente igual al que se aprecia por los oculares.
✅ La información de escala correcta se añade automáticamente.
✅ Trabaje cómodamente con una ergonomía adaptable.
Aumente su eficiencia con la microscopía inteligente
Cuando encuentre una región de interés, pulse el botón de captura situado en el estativo para obtener la imagen. Así de simple. Axiolab 5 le ofrece un concepto de manipulación sencilla y uso ergonómico adaptado a su trabajo cotidiano en el laboratorio.
Controle el microscopio y la cámara que lleva acoplada sin necesidad de cambiar la sujeción. El sistema inteligente del microscopio ajusta los parámetros de forma automática y documenta la muestra con precisión mientras usted la observa por los oculares, con todos los detalles y un color fidedigno.
La escala correcta siempre se incluye automáticamente. No tendrá que invertir en otro ordenador ni en más software. Con la microscopía inteligente, trabajará con mayor eficiencia y podrá concentrarse en la muestra en todo momento.
Más económico y fiable
En lo que respecta al ahorro de costes y energía, Axiolab 5 está de su parte. Por ejemplo, si activa el modo Eco, Axiolab 5 pasará automáticamente al modo de reposo cuando se encuentre inactivo durante 15 minutos. Su concepto inteligente de iluminación también le ayuda a mejorar la eficiencia en el laboratorio. El gestor de luz proporciona un brillo uniforme en todos los aumentos y se puede configurar incluso para diferentes contrastes.
La iluminación LED blanca de gran potencia con un índice de renderizado del color muy alto le permite visualizar la muestra en su color original. La temperatura de color constante del LED facilita el funcionamiento del sistema y la documentación digital. Para la fluorescencia, los potentes LED de diversas longitudes de onda son eficientes desde el punto de vista energético y son más fáciles de manejar que la iluminación HBO convencional.
Los LED también le evitarán tiempo de calentamiento y enfriamiento, sustitución y ajustes de la lámpara.
Ergonomía ingeniosa para trabajar con tranquilidad en el laboratorio
Axiolab 5 destaca en cuanto a ergonomía y eficiencia. Con una sola mano podrá acceder a todos los controles principales, como el botón de captura, el portamuestras, el ajuste de enfoque y el control de luminosidad, entre otros.
Los tubos ergonómicos y la platina sin soportes con altura y torsión adaptables permiten trabajar en una posición cómoda, incluso durante largas horas.
Solo tiene que ajustar la altura de visualización para encontrar la posición más cómoda. Gracias al portamuestras doble, se ahorrará cambiar continuamente las muestras (por ejemplo, al examinar muestras IHC), por lo que se cansará menos.
En resumen, Axiolab 5 minimiza y simplifica los pasos manuales para trabajar de forma más eficiente y cómoda.
Aumente su eficiencia
Con Smart Microscopy
Obtener imágenes detalladas con color fidedigno puede llevar mucho tiempo. Ya conoce la rutina: colocar la muestra; enfocar la región de interés; pasar al ordenador; establecer ajustes tales como el balance de blancos, tiempo de exposición y ganancia; obtener una imagen; insertar una barra de escala; regresar al microscopio; etc.
Así es el flujo de trabajo habitual de documentación. Ahora, con el sistema Axiolab 5, podrá centrarse en la muestra en todo momento gracias a la microscopía inteligente. La documentación digital es inherente al diseño del sistema. Solo tiene que pulsar el botón ergonómico de captura del microscopio y listo. El procedimiento se integra perfectamente en el flujo de trabajo de microscopía establecido y aumentará enormemente su eficiencia.
Cómo usar un lector de código de barras con Smart Microscopy
en modo independiente
La gestión precisa y sin complicaciones de los datos es la clave cuando se enfrenta a un volumen de muestras elevado o a datos sensibles: necesita trabajar con rapidez y con una precisión total de los datos.
Ahí es donde entra en juego el etiquetado del código de barras, que le ayuda a procesar incluso grandes cantidades de muestras con gran facilidad y fiabilidad. Su microscopio inteligente de ZEISS le permite asignar imágenes de microscopio con la información de escala correcta a muestras etiquetadas con códigos de barras. Solo tiene que usar su microscopio Axiolab 5 o Axioscope 5 con un ordenador de Windows o iPad, conectar un lector de códigos de barras a su cámara de microscopio Axiocam 208 color y listo para trabajar.
Cómo escanear un código de barras con Labscope y Smart Microscopy
La gestión precisa y sin complicaciones de los datos es la clave cuando se enfrenta a un volumen de muestras elevado o a datos sensibles: necesita trabajar con rapidez y con una precisión total de los datos. Ahí es donde entra en juego el etiquetado del código de barras, que le ayuda a procesar incluso grandes cantidades de muestras con gran facilidad y fiabilidad.
Solo tiene que usar su microscopio Axiolab 5 o Axioscope 5 con una cámara Axiocam 208 color y conectarlo a su iPad. Al escanear el código de barras con la cámara integrada del iPad, Labscope asignará esa ID particular del código de barras a la imagen captada.
Ergonomía
El primer párrafo describe el entorno de un laboratorio clínico o biomédico, destacando la presión que existe para evaluar rápidamente un gran número de muestras de tejido de pacientes. Señala que esta tarea es muy exigente y que pasar mucho tiempo sentado frente al microscopio puede afectar negativamente la comodidad y el bienestar de la persona.
El segundo párrafo enfatiza la importancia de mantener una postura cómoda y relajada para la salud en general. Como solución, menciona los tubos ergonómicos ZEISS, diseñados específicamente para garantizar una postura óptima, lo que ayuda a reducir la tensión y la fatiga.
Tres configuraciones disponibles
Con Axiolab 5 está preparado para hoy y para el futuro. Elija la configuración que mejor se adapta a su flujo de trabajo de laboratorio:

Funcionamiento independiente para la captura básica de imágenes en el trabajo diario
El párrafo explica que el microscopio Axiolab 5, cuando se combina con las cámaras Axiocam 202 mono o Axiocam 208 color, puede funcionar de manera autónoma, es decir, sin necesidad de un sistema informático (un ordenador) para realizar la captura de imágenes.

ZEISS Labscope para la captura de imágenes avanzada en el trabajo diario
El párrafo explica que el uso del microscopio ZEISS Axiolab 5 junto con la aplicación de captura de imágenes ZEISS Labscope es ideal para dos aplicaciones específicas: la microscopía conectada y la captura de imágenes de fluorescencia multicanal convencional.

ZEISS ZEN para aplicaciones de investigación
El párrafo indica que se debe usar el software de captura de imágenes ZEN de ZEISS para llevar a cabo el procesamiento y análisis adicional de las imágenes.
ZEISS Axiolab 5 en funcionamiento
Información sobre el producto

ZEISS Axiolab 5
El microscopio inteligente que agiliza el trabajo en el laboratorio

Microscopio ZEISS para Citopatología
Detecta enfermedades a nivel celular
Microscopios ZEISS para Hematología
Estudia la sangre y las enfermedades de la sangre

Microscopios ZEISS para Histología
Examine las morfologías de los tejidos

Sus microscopios para su laboratorio biomédico.
Sus microscopios para una mayor eficiencia en el laboratorio.
Documentos técnicos

Baumgartner – la Cerveza de la Región de Innviertel
Control de calidad con ZEISS Axiolab

Análisis Microscópico de Orina
ZEISS Primostar 3 y ZEISS Axiolab

Análisis microscópico del polen en la miel
Identificación y documentación con ZEISS Axiolab

Anatomía Microscópica en el Estudio de la Medicina
Fundamentos de Histología
